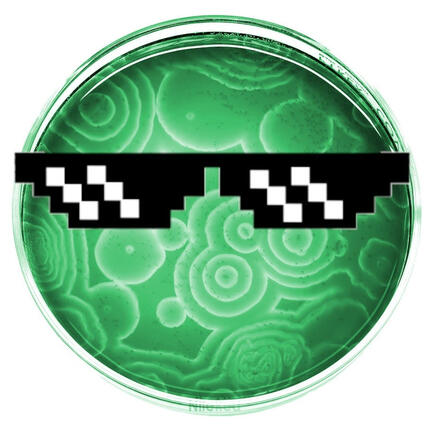
MrGreen

Books wow I like books so much 💖 bet you didn't expect a guy like me, Xan, to read.
Favorite musicians
In no particular order. It's surprising how some of these people are connected... 👀 Last.fm
-

AJR
-

Bo Burnham
-

Daft Punk
-

Danny Gonzalez
-

Inabakumori
-

Kaden MacKay
-

Lemon Demon
-

Metric
-

Oliver Tree
-

Tally Hall
-

The Rare Occasions
-

Miracle Musical
-

Jack Stauber
-

CG5
-

Cosmo Sheldrake
-

bo en
-

Louie Zong
-

C418
-

Caravan Palace
-

Exyl
-

Vantage
-

Shawn Wasabi
-

Molina
-

DROELOE
-

Easy Life
-

Hans Zimmer
-

Keanu Silva
-

Snails House
-

half•alive
-

Gorillaz
-

The Happy Fits
-

Elohim
-

Siamés
-

BETWEEN FRIENDS
-

The Living Tombstone
-

I Dont Know How But They Found Me
-

The Correspondents
-

Saint Motel
-

Jukebox the Ghost
-

Glass Animals
-

Will Wood
-

The Hoosiers
-

Fish in a Birdcage
-

Weathers
-

Fitz and The Tantrums
-

Kiltro
-

That Handsome Devil
-

Mad Tsai
-

Toby Fox
-

Leon Chang
-

Tsundere Labs Inc
-

BENEE
-

mxmtoon
-

Cavetown
-

Tessa Violet
-

Rick Astley
Youtubers and other content creators
I literally cannot list the hundreds (at least half a thousand) of people I'm subscribed to. Also, some musicians aren't listed here and some YouTubers aren't listed there. YouTube
-

Jakerton
-

Jimmy Here
-

Crispy Concords
-

Mrwhosetheboss
-

Skeppy
-

jackfilms
-

Adam Conover
-

Jaden Williams
-

matpat
-

Anthony Padilla
-

rekrap2
-
MrGreen
-

Tommyinnit
-

TechLinked
-

MrBeast
-

Ludwig
-

Gingerpale
-

Lunarism
-

Barji
-

savannahXYZ
-

Randy Feltface
-

Knarfy
-

Degenerocity
-

Google
-

justmehabibi
-

Discord
-

MLGaeming
-

Doni Bobes
-

MattColbo
-

Ryan Reynolds
-

College Humor
-

Sam Beckman
-

Tom Scott
-

Manny Meachum
-

Satori Graphics
-

The Spiffing Brit
-

Corridor Crew
-

Wilbur Soot
-

Ice Cream Sandwich
-

Captain Disallusion
-

Mental Checkpoint
-

Vlog Creations
-

Krugston
-

Disrupt
-

Jschlatt
-

Gawx Art
-

Dani
-

Hyperplexed
-

BENOFTHEWEEK
-

Seytonic
-

Matt & Justus
-

Markiplier
-

elliotisacoolguy
-

Jack Rhysider
-

SMii7Y
-

Magnates Media
Feature films and series I've enjoyed
Randomly put here with poor memory.
Good books that I read
I've read a lot more than these books, but I could only remember a few. I have a tracker now so I can keep track of all of them.
-

The Darkness Outside Us
-

The Golden Compass
-

Honor Among Thieves
-

They Both Die At The End
-

Artemis Fowl
-

Unremembered
-

Wundersmith
-

Game Changer
-

Dragon Pearl
-

A Monster Calls
-

Catching Fire
-

What if?
-

The Supernatural Enhancements
-

The Eyes of the Dragon
-

We're Talking Millions!
-

So Long, and Thanks for All the Fish
Fun games I've played
Wow, what fun. 🤯 Steam
You want to visit my website?
Yes, you do: xan.lol | Made by the person who made this one.
This website was inspired by Spotify
I use Retro Music & YouTube Music instead.
Want to take a look at Retro Music? Swaggy 👀!
uh oh
I think you might've clicked the wrong button...
☠
All of a sudden, silence.You knew you had made a mistake...
But, at what cost?
































